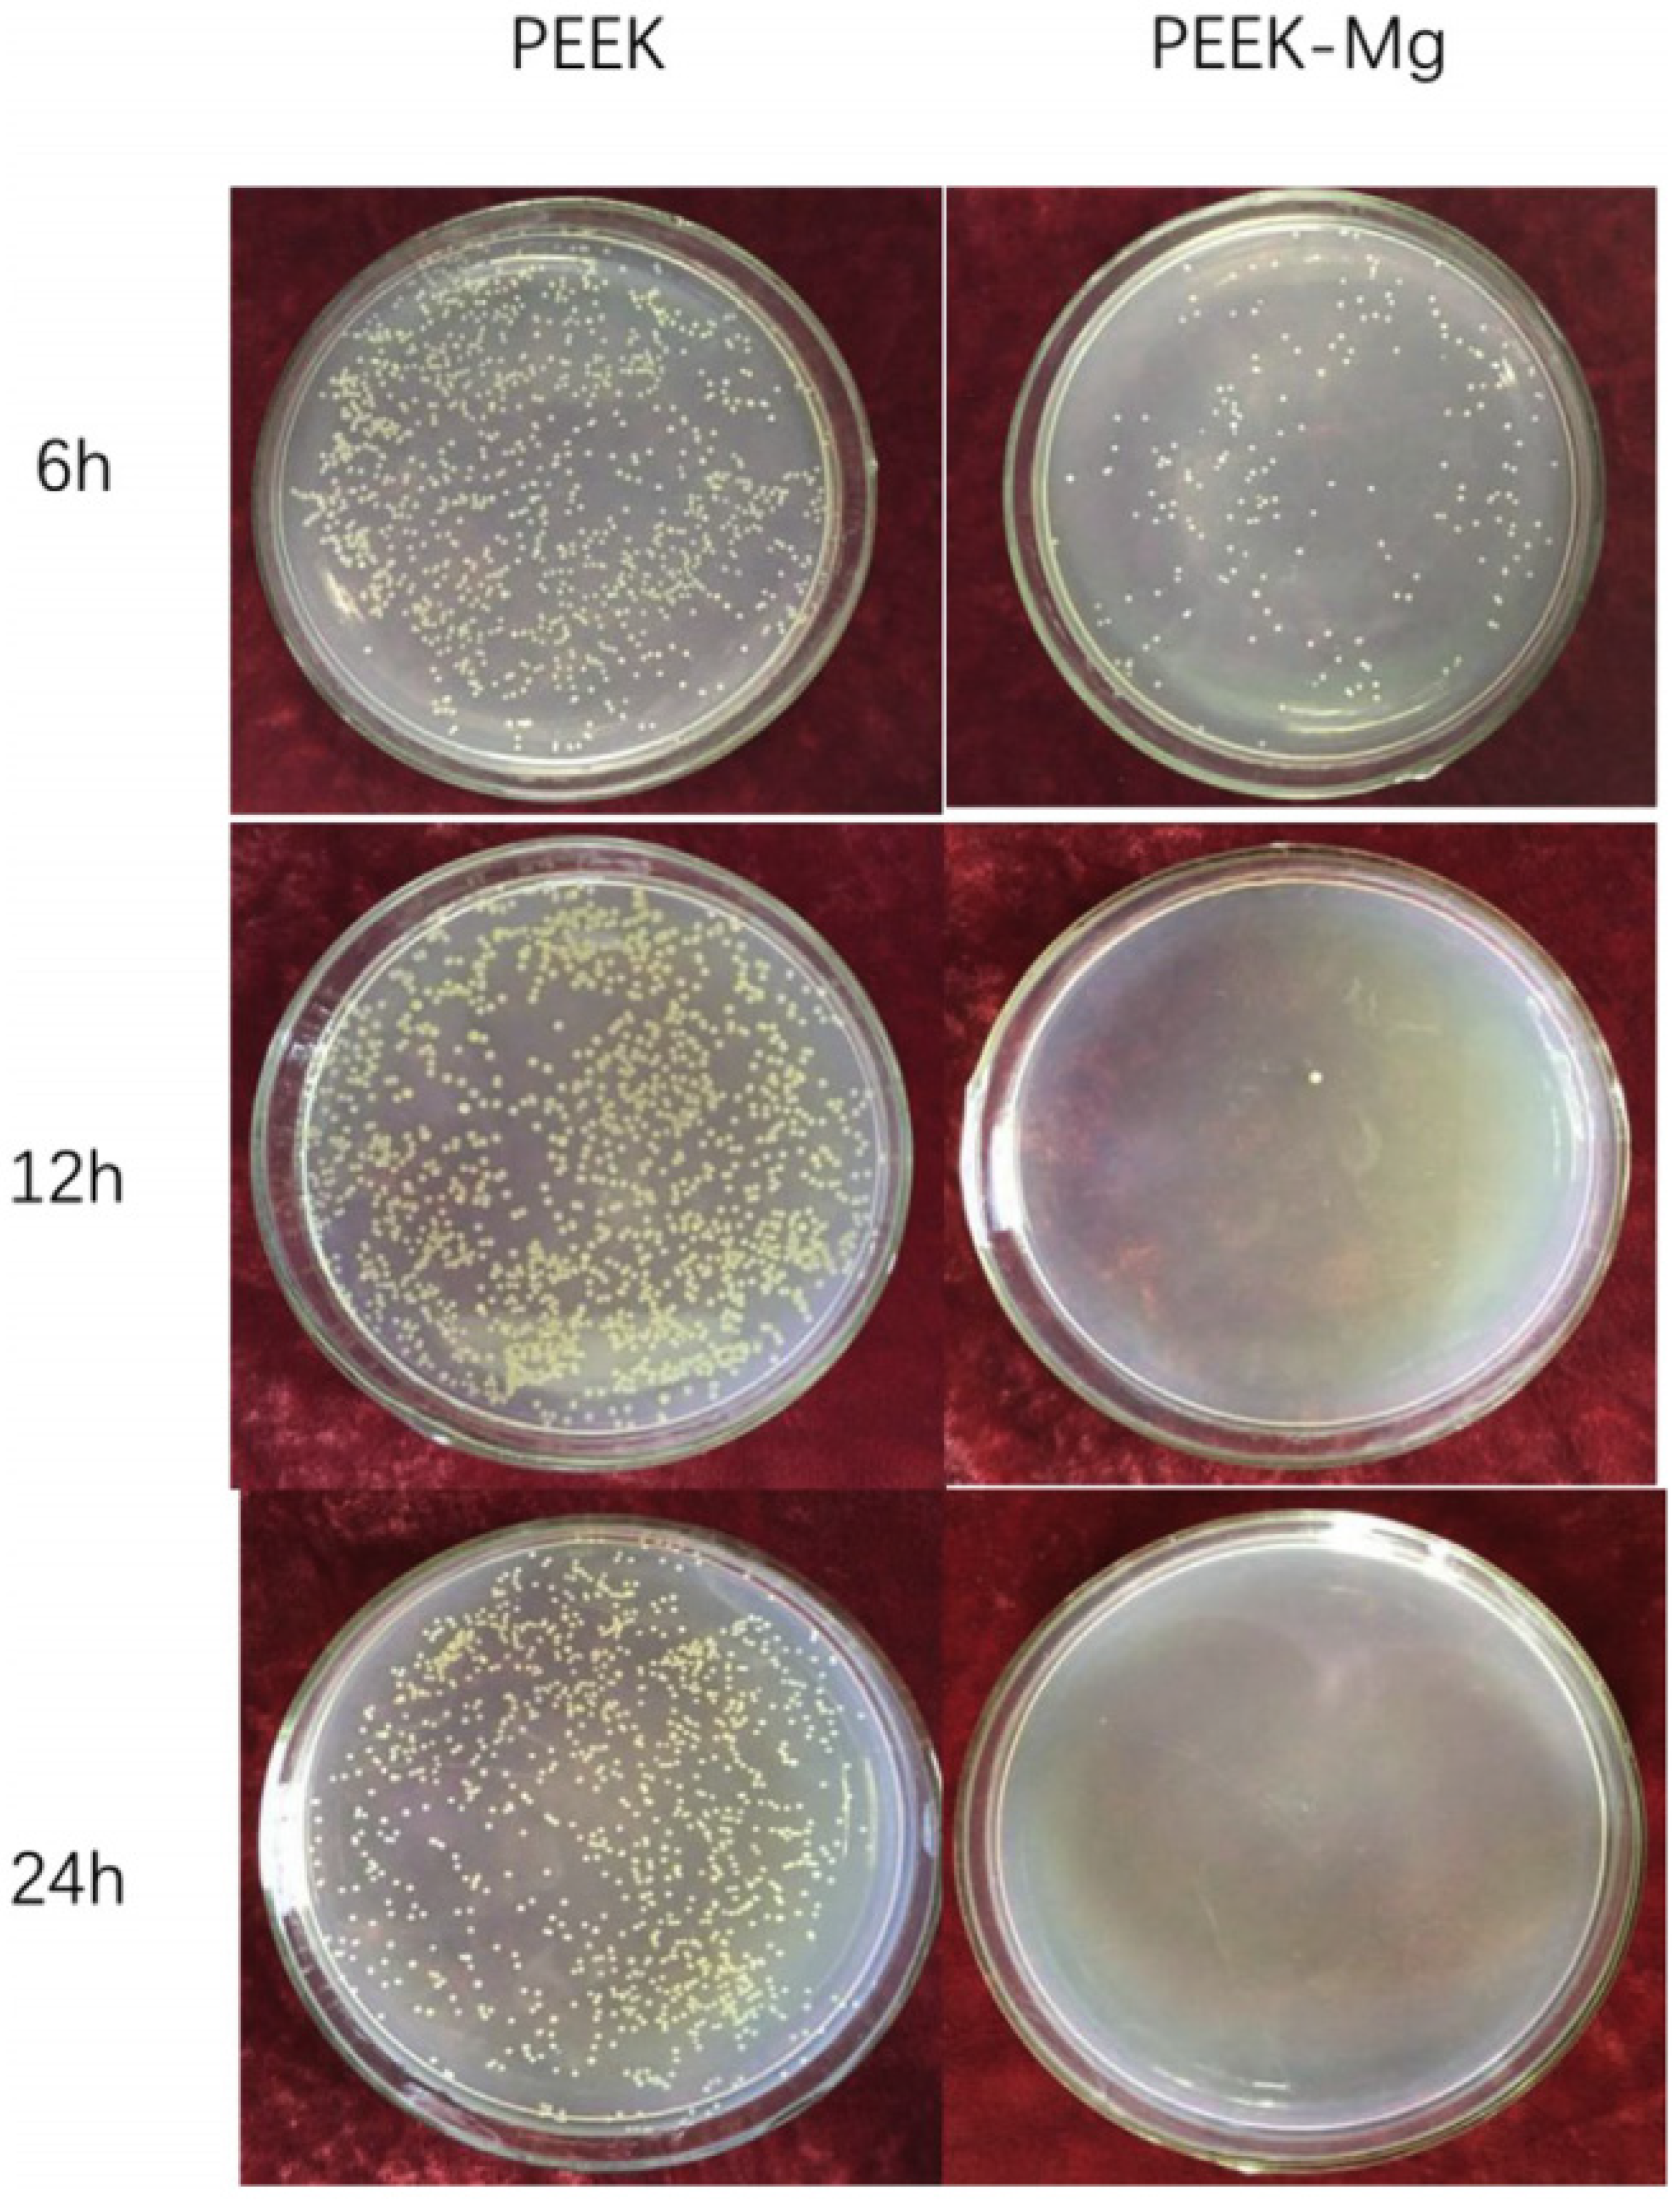
Coatings 13 00977 g001

Surface Modification Techniques for Polyetheretherketone as Spinal Interbody Fusion Cage Material to Stimulate Biological Response: A Review
Abstract
:1. Introduction
2. Surface Modification
2.1. Physical Modification
2.1.1. Physical Vapor Deposition (PVD)
2.1.2. Plasma Treatment
2.1.3. Accelerating Neutral Atomic Beam (ANAB) Technology
2.2. Chemical Modification
2.2.1. Sulfonation and Other Acid Treatment
2.2.2. Ultraviolet Radiation Grafting
2.2.3. Biological Molecules
2.3. Surface Coating
2.3.1. Metal Coating
2.3.2. Hydroxyapatite Coating
2.3.3. Dopamine Composite Coating
2.3.4. Other Kinds of Coatings
3. Conclusions and Outlook
Author Contributions
Funding
Institutional Review Board Statement
Informed Consent Statement
Data Availability Statement
Acknowledgments
Conflicts of Interest
References
- Cloward, R.B. The treatment of ruptured lumbar intervertebral discs by vertebral body fusion. I. Indications, operative technique, after care. J. Neurosurg. 1953, 10, 154–168. [Google Scholar] [CrossRef] [PubMed]
- Smith, G.W.; Robinson, R.A. The treatment of certain cervical-spine disorders by anterior removal of the intervertebral disc and interbody fusion. J. Bone Jt. Surg. Am. 1958, 40-A, 607–624. [Google Scholar] [CrossRef]
- Abou-Madawi, A.M.; Ali, S.H.; Abdelmonem, A.M. Local Autograft Versus Iliac Crest Bone Graft PSF-Augmented TLIF in Low-Grade Isthmic and Degenerative Lumbar Spondylolisthesis. Glob. Spine J. 2022, 12, 70–78. [Google Scholar] [CrossRef]
- Park, K.H.; Chung, H.W.; Lee, H.D.; Jeon, C.H.; Koh, J.H.; Chung, N.S. Cage Obliquity and Radiological Outcomes in Oblique Lateral Interbody Fusion. Spine 2022. ahead of print. [Google Scholar] [CrossRef]
- Bagby, G.W. Arthrodesis by the distraction-compression method using a stainless steel implant. Orthopedics 1988, 11, 931–934. [Google Scholar] [CrossRef] [PubMed]
- Kuslich, S. Two-year follow up results of the BAK interbody fusion device. In Proceedings of the Meeting of the North American Spine Society, Minneapolis, MN, USA, 19–22 October 1994. [Google Scholar]
- Epstein, N.E.; Agulnick, M.A. Review of anterior cervical diskectomy/fusion (ACDF) using different polyetheretherketone (PEEK) cages. Surg. Neurol. Int. 2022, 13, 556. [Google Scholar] [CrossRef] [PubMed]
- Segi, N.; Nakashima, H.; Shinjo, R.; Kagami, Y.; Machino, M.; Ito, S.; Ouchida, J.; Morishita, K.; Oishi, R.; Yamauchi, I.; et al. Vertebral Endplate Concavity in Lateral Lumbar Interbody Fusion: Tapered 3D-Printed Porous Titanium Cage versus Squared PEEK Cage. Medicina 2023, 59, 327. [Google Scholar] [CrossRef] [PubMed]
- Zhou, E.; Huang, H.; Zhao, Y.; Wang, L.; Fan, Y. The effects of titanium mesh cage size on the biomechanical responses of cervical spine after anterior cervical corpectomy and fusion: A finite element study. Clin. Biomech. 2022, 91, 105547. [Google Scholar] [CrossRef]
- Muthiah, N.; Yolcu, Y.U.; Alan, N.; Agarwal, N.; Hamilton, D.K.; Ozpinar, A. Evolution of polyetheretherketone (PEEK) and titanium interbody devices for spinal procedures: A comprehensive review of the literature. Eur. Spine J. 2022, 31, 2547–2556. [Google Scholar] [CrossRef]
- Erjavec, A.K.; Črešnar, K.P.; Švab, I.; Vuherer, T.; Žigon, M.; Brunčko, M. Determination of Shear Bond Strength between PEEK Composites and Veneering Composites for the Production of Dental Restorations. Materials 2023, 16, 3286. [Google Scholar] [CrossRef]
- Wiessner, A.; Wassmann, T.; Wiessner, J.M.; Schubert, A.; Wiechens, B.; Hampe, T.; Bürgers, R. In Vivo Biofilm Formation on Novel PEEK, Titanium, and Zirconia Implant Abutment Materials. Int. J. Mol. Sci. 2023, 24, 1779. [Google Scholar] [CrossRef] [PubMed]
- Dondani, J.R.; Iyer, J.; Tran, S.D. Surface Treatments of PEEK for Osseointegration to Bone. Biomolecules 2023, 13, 464. [Google Scholar] [CrossRef] [PubMed]
- Veronesi, F.; Sartori, M.; Griffoni, C.; Valacco, M.; Tedesco, G.; Davassi, P.F.; Gasbarrini, A.; Fini, M.; Barbanti Brodano, G. Complications in Spinal Fusion Surgery: A Systematic Review of Clinically Used Cages. J. Clin. Med. 2022, 11, 6279. [Google Scholar] [CrossRef] [PubMed]
- Zhang, H.; Duan, M.; Qin, S.; Zhang, Z. Preparation and Modification of Porous Polyetheretherketone (PEEK) Cage Material Based on Fused Deposition Modeling (FDM). Polymers 2022, 14, 5403. [Google Scholar] [CrossRef] [PubMed]
- Münstedt, H.; Grossmann, J. Surface Modifications of Polyetheretherketone (PEEK): Results from the Literature and Special Studies of Copper-Coated Films. Polymers 2022, 14, 4797. [Google Scholar] [CrossRef]
- Lisoń, J.; Taratuta, A.; Paszenda, Z.; Szindler, M.; Basiaga, M. Perspectives in Prevention of Biofilm for Medical Applications. Coatings 2022, 12, 197. [Google Scholar] [CrossRef]
- Yu, X.; Ibrahim, M.; Liu, Z.; Yang, H.; Tan, L.; Yang, K. Biofunctional Mg coating on PEEK for improving bioactivity. Bioact. Mater. 2018, 3, 139–143. [Google Scholar] [CrossRef]
- Kratochvíl, J.; Štěrba, J.; Lieskovská, J.; Langhansová, H.; Kuzminova, A.; Khalakhan, I.; Kylián, O.; Straňák, V. Antibacterial effect of Cu/C:F nanocomposites deposited on PEEK substrates. Mater. Lett. 2018, 230, 96–99. [Google Scholar] [CrossRef]
- Durham, J.W.; Allen, M.J.; Rabiei, A. Preparation, characterization and in vitro response of bioactive coatings on polyether ether ketone. J. Biomed. Mater. Res. Part B Appl. Biomater. 2017, 105, 560–567. [Google Scholar] [CrossRef]
- Briem, D.; Strametz, S.; Schröoder, K.; Meenen, N.M.; Lehmann, W.; Linhart, W.; Ohl, A.; Rueger, J.M. Response of primary fibroblasts and osteoblasts to plasma treated polyetheretherketone (PEEK) surfaces. J. Mater. Sci. Mater. Med. 2005, 16, 671–677. [Google Scholar] [CrossRef]
- Recek, N. Biocompatibility of Plasma-Treated Polymeric Implants. Materials 2019, 12, 240. [Google Scholar] [CrossRef] [PubMed]
- Chen, J.-P.; Su, C.-H. Surface modification of electrospun PLLA nanofibers by plasma treatment and cationized gelatin immobilization for cartilage tissue engineering. Acta Biomater. 2011, 7, 234–243. [Google Scholar] [CrossRef] [PubMed]
- Waser-Althaus, J.; Salamon, A.; Waser, M.; Padeste, C.; Kreutzer, M.; Pieles, U.; Müller, B.; Peters, K. Differentiation of human mesenchymal stem cells on plasma-treated polyetheretherketone. J. Mater. Sci. Mater. Med. 2014, 25, 515–525. [Google Scholar] [CrossRef] [PubMed]
- Novotna, Z.; Reznickova, A.; Rimpelova, S.; Vesely, M.; Kolska, Z.; Svorcik, V. Tailoring of PEEK bioactivity for improved cell interaction: Plasma treatment in action. RSC Adv. 2015, 5, 41428–41436. [Google Scholar] [CrossRef]
- Poulsson, A.H.; Eglin, D.; Zeiter, S.; Camenisch, K.; Sprecher, C.; Agarwal, Y.; Nehrbass, D.; Wilson, J.; Richards, R.G. Osseointegration of machined, injection moulded and oxygen plasma modified PEEK implants in a sheep model. Biomaterials 2014, 35, 3717–3728. [Google Scholar] [CrossRef] [PubMed]
- Zhao, Y.; Wong, H.M.; Lui, S.C.; Chong, E.Y.W.; Wu, G.; Zhao, X.; Wang, C.; Pan, H.; Cheung, K.M.C.; Wu, S.; et al. Plasma Surface Functionalized Polyetheretherketone for Enhanced Osseo-Integration at Bone-Implant Interface. ACS Appl. Mater. Interfaces 2016, 8, 3901–3911. [Google Scholar] [CrossRef] [PubMed]
- Petlin, D.; Tverdokhlebov, S.; Anissimov, Y. Plasma treatment as an efficient tool for controlled drug release from polymeric materials: A review. J. Control. Release 2017, 266, 57–74. [Google Scholar] [CrossRef]
- Pidhatika, B.; Widyaya, V.T.; Nalam, P.C.; Swasono, Y.A.; Ardhani, R. Surface Modifications of High-Performance Polymer Polyetheretherketone (PEEK) to Improve Its Biological Performance in Dentistry. Polymers 2022, 14, 5526. [Google Scholar] [CrossRef]
- Liu, L.; Khoury, J.; Webster, T.J. Accelerated Neutral Atom Beam (ANAB) Modified Polypropylene for Reducing Bacteria Colonization Without Antibiotics. J. Biomed. Nanotechnol. 2022, 18, 868–874. [Google Scholar] [CrossRef]
- Ajami, S.; Coathup, M.J.; Khoury, J.; Blunn, G.W. Augmenting the bioactivity of polyetheretherketone using a novel accelerated neutral atom beam technique. J. Biomed. Mater. Res. Part B Appl. Biomater. 2017, 105, 1438–1446. [Google Scholar] [CrossRef]
- Khoury, J.; Selezneva, I.; Pestov, S.; Tarassov, V.; Ermakov, A.; Mikheev, A.; Lazov, M.; Kirkpatrick, S.R.; Shashkov, D.; Smolkov, A. Surface bioactivation of PEEK by neutral atom beam technology. Bioact. Mater. 2019, 4, 132–141. [Google Scholar] [CrossRef] [PubMed]
- Khoury, J.; Maxwell, M.; Cherian, R.E.; Bachand, J.; Kurz, A.C.; Walsh, M.; Assad, M.; Svrluga, R.C. Enhanced bioactivity and osseointegration of PEEK with accelerated neutral atom beam technology. J. Biomed. Mater. Res. Part B Appl. Biomater. 2017, 105, 531–543. [Google Scholar] [CrossRef] [PubMed]
- Buck, E.; Lee, S.; Gao, Q.; Tran, S.D.; Tamimi, F.; Stone, L.S.; Cerruti, M. The Role of Surface Chemistry in the Osseointegration of PEEK Implants. ACS Biomater. Sci. Eng. 2022, 8, 1506–1521. [Google Scholar] [CrossRef] [PubMed]
- Zheng, Z.; Liu, P.; Zhang, X.; Xin, J.; Wang, Y.; Zou, X.; Mei, X.; Zhang, S.; Zhang, S. Strategies to improve bioactive and antibacterial properties of polyetheretherketone (PEEK) for use as orthopedic implants. Mater. Today Bio 2022, 16, 100402. [Google Scholar] [CrossRef]
- Huang, R.Y.M.; Shao, P.; Burns, C.M.; Feng, X. Sulfonation of poly(ether ether ketone)(PEEK): Kinetic study and characterization. J. Appl. Polym. Sci. 2001, 82, 2651–2660. [Google Scholar] [CrossRef]
- Shi, Y.; Deng, T.; Peng, Y.; Qin, Z.; Ramalingam, M.; Pan, Y.; Chen, C.; Zhao, F.; Cheng, L.; Liu, J. Effect of Surface Modification of PEEK Artificial Phalanx by 3D Printing on its Biological Activity. Coatings 2023, 13, 400. [Google Scholar] [CrossRef]
- Ouyang, L.; Zhao, Y.; Jin, G.; Lu, T.; Li, J.; Qiao, Y.; Ning, C.; Zhang, X.; Chu, P.K.; Liu, X. Influence of sulfur content on bone formation and antibacterial ability of sulfonated PEEK. Biomaterials 2016, 83, 115–126. [Google Scholar] [CrossRef]
- Wang, C.; Wang, J.; Zeng, L.; Qiao, Z.; Liu, X.; Liu, H.; Zhang, J.; Ding, J. Fabrication of Electrospun Polymer Nanofibers with Diverse Morphologies. Molecules 2019, 24, 834. [Google Scholar] [CrossRef]
- Xin, H.; Shi, Q.; Ning, X.; Chen, Y.; Jia, X.; Zhang, Z.; Zhu, S.; Li, Y.; Liu, F.; Kong, L. Biomimetic Mineralized Fiber Bundle-Inspired Scaffolding Surface on Polyetheretherketone Implants Promotes Osseointegration. Macromol. Biosci. 2023, 23, e2200436. [Google Scholar] [CrossRef]
- Zhao, Y.; Wong, H.M.; Wang, W.; Li, P.; Xu, Z.; Chong, E.Y.; Yan, C.H.; Yeung, K.W.; Chu, P.K. Cytocompatibility, osseointegration, and bioactivity of three-dimensional porous and nanostructured network on polyetheretherketone. Biomaterials 2013, 34, 9264–9277. [Google Scholar] [CrossRef]
- Baltag, L.; Cojocaru, C.; Enache, A.-C.; Samoila, P.; Harabagiu, V. Ultrasonic-Assisted Rapid Preparation of Sulfonated Polyether Ether Ketone (PEEK) and Its Testing in Adsorption of Cationic Species from Aqueous Solutions. Materials 2022, 15, 7558. [Google Scholar] [CrossRef] [PubMed]
- Wan, T.; Jiao, Z.; Guo, M.; Wang, Z.; Wan, Y.; Lin, K.; Liu, Q.; Zhang, P. Gaseous sulfur trioxide induced controllable sulfonation promoting biomineralization and osseointegration of polyetheretherketone implants. Bioact. Mater. 2020, 5, 1004–1017. [Google Scholar] [CrossRef] [PubMed]
- Huo, S.; Meng, X.; Zhang, S.; Yue, B.; Zhao, Y.; Long, T.; Nie, B.; Wang, Y. Hydrofluoric acid and nitric acid cotreatment for biofunctionalization of polyetheretherketone in M2 macrophage polarization and osteogenesis. J. Biomed. Mater. Res. Part A 2021, 109, 879–892. [Google Scholar] [CrossRef] [PubMed]
- Li, Y.; Wang, J.; He, D.; Zhu, G.; Wu, G.; Chen, L. Surface sulfonation and nitrification enhance the biological activity and osteogenesis of polyetheretherketone by forming an irregular nano-porous monolayer. J. Mater. Sci. Mater. Med. 2019, 31, 11. [Google Scholar] [CrossRef]
- Flejszar, M.; Chmielarz, P. Surface Modifications of Poly(Ether Ether Ketone) via Polymerization Methods—Current Status and Future Prospects. Materials 2020, 13, 999. [Google Scholar] [CrossRef] [PubMed]
- Nakano, H.; Noguchi, Y.; Kakinoki, S.; Yamakawa, M.; Osaka, I.; Iwasaki, Y. Highly Durable Lubricity of Photo-Cross-Linked Zwitterionic Polymer Brushes Supported by Poly(ether ether ketone) Substrate. ACS Appl. Bio Mater. 2020, 3, 1071–1078. [Google Scholar] [CrossRef]
- Liu, L.; Dong, J.; Zhang, W.; He, C.; Liu, Y.; Zheng, Y. The Single-Step Fabrication of a Poly (Sodium Vinylsulfonate)-Grafted Polyetheretherketone Surface to Ameliorate Its Osteogenic Activity. Coatings 2022, 12, 868. [Google Scholar] [CrossRef]
- Zhao, X.; Xiong, D.; Wang, K.; Wang, N. Improved biotribological properties of PEEK by photo-induced graft polymerization of acrylic acid. Mater. Sci. Eng. C 2017, 75, 777–783. [Google Scholar] [CrossRef]
- Zheng, Y.; Liu, L.; Xiao, L.; Zhang, Q.; Liu, Y. Enhanced osteogenic activity of phosphorylated polyetheretherketone via surface-initiated grafting polymerization of vinylphosphonic acid. Colloids Surf. B Biointerfaces 2019, 173, 591–598. [Google Scholar] [CrossRef]
- Liu, S.; Zhu, Y.; Gao, H.; Ge, P.; Ren, K.; Gao, J.; Cao, Y.; Han, D.; Zhang, J. One-step fabrication of functionalized poly(etheretherketone) surfaces with enhanced biocompatibility and osteogenic activity. Mater. Sci. Eng. C 2018, 88, 70–78. [Google Scholar] [CrossRef]
- Saad, A.; Arias, C.P.; Wang, M.; ElKashty, O.; Brambilla, D.; Tamimi, F.; Cerruti, M. Biomimetic Strategy to Enhance Epithelial Cell Viability and Spreading on PEEK Implants. ACS Biomater. Sci. Eng. 2022, 8, 5129–5144. [Google Scholar] [CrossRef] [PubMed]
- Wetzell, B.; McLean, J.B.; Moore, M.A.; Kondragunta, V.; Dorsch, K. A large database study of hospitalization charges and follow-up re-admissions in US lumbar fusion surgeries using a cellular bone allograft (CBA) versus recombinant human bone morphogenetic protein-2 (rhBMP-2). J. Orthop. Surg. Res. 2020, 15, 544. [Google Scholar] [CrossRef] [PubMed]
- Wu, J.; Li, L.; Fu, C.; Yang, F.; Jiao, Z.; Shi, X.; Ito, Y.; Wang, Z.; Liu, Q.; Zhang, P. Micro-porous polyetheretherketone implants decorated with BMP-2 via phosphorylated gelatin coating for enhancing cell adhesion and osteogenic differentiation. Colloids Surf. B Biointerfaces 2018, 169, 233–241. [Google Scholar] [CrossRef] [PubMed]
- Sun, Z.; Ouyang, L.; Ma, X.; Qiao, Y.; Liu, X. Controllable and durable release of BMP-2-loaded 3D porous sulfonated polyetheretherketone (PEEK) for osteogenic activity enhancement. Colloids Surf. B Biointerfaces 2018, 171, 668–674. [Google Scholar] [CrossRef] [PubMed]
- James, A.W.; LaChaud, G.; Shen, J.; Asatrian, G.; Nguyen, V.; Zhang, X.; Ting, K.; Soo, C. A Review of the Clinical Side Effects of Bone Morphogenetic Protein-2. Tissue Eng. Part B Rev. 2016, 22, 284–297. [Google Scholar] [CrossRef] [PubMed]
- Guillot, R.; Pignot-Paintrand, I.; Lavaud, J.; Decambron, A.; Bourgeois, E.; Josserand, V.; Logeart-Avramoglou, D.; Viguier, E.; Picart, C. Assessment of a polyelectrolyte multilayer film coating loaded with BMP-2 on titanium and PEEK implants in the rabbit femoral condyle. Acta Biomater. 2016, 36, 310–322. [Google Scholar] [CrossRef] [PubMed]
- Hume, R.D.; Kanagalingam, S.; Deshmukh, T.; Chen, S.; Mithieux, S.M.; Rashid, F.N.; Roohani, I.; Lu, J.; Doan, T.; Graham, D.; et al. Tropoelastin Improves Post-Infarct Cardiac Function. Circ. Res. 2023, 132, 72–86. [Google Scholar] [CrossRef]
- Meng, S.; Tang, C.; Deng, M.; Yuan, J.; Fan, Y.; Gao, S.; Feng, Y.; Yang, J.; Chen, C. Tropoelastin-Pretreated Exosomes from Adipose-Derived Stem Cells Improve the Synthesis of Cartilage Matrix and Alleviate Osteoarthritis. J. Funct. Biomater. 2023, 14, 203. [Google Scholar] [CrossRef]
- Yeo, G.C.; Santos, M.; Kondyurin, A.; Liskova, J.; Weiss, A.S.; Bilek, M.M.M. Plasma-Activated Tropoelastin Functionalization of Zirconium for Improved Bone Cell Response. ACS Biomater. Sci. Eng. 2016, 2, 662–676. [Google Scholar] [CrossRef]
- Al Halawani, A.; Abdulkhalek, L.; Mithieux, S.M.; Weiss, A.S. Tropoelastin Promotes the Formation of Dense, Interconnected Endothelial Networks. Biomolecules 2021, 11, 1318. [Google Scholar] [CrossRef]
- Wakelin, E.A.; Yeo, G.C.; McKenzie, D.R.; Bilek, M.M.M.; Weiss, A.S. Plasma ion implantation enabled bio-functionalization of PEEK improves osteoblastic activity. APL Bioeng. 2018, 2, 026109. [Google Scholar] [CrossRef] [PubMed]
- Wang, C.; Wang, S.; Yang, Y.; Jiang, Z.; Deng, Y.; Song, S.; Yang, W.; Chen, Z.-G. Bioinspired, biocompatible and peptide-decorated silk fibroin coatings for enhanced osteogenesis of bioinert implant. J. Biomater. Sci. Polym. Ed. 2018, 29, 1595–1611. [Google Scholar] [CrossRef]
- Wang, S.; Yang, Y.; Li, Y.; Shi, J.; Zhou, J.; Zhang, L.; Deng, Y.; Yang, W. Strontium/adiponectin co-decoration modulates the osteogenic activity of nano-morphologic polyetheretherketone implant. Colloids Surf. B Biointerfaces 2019, 176, 38–46. [Google Scholar] [CrossRef] [PubMed]
- Boonpok, S.; Koonrungsrisomboon, K.; Suttiat, K.; Yavirach, P.; Boonyawan, D. Dissolution Behavior of Hydrothermally Treated Hydroxyapatite–Titanium Nitride Films Coated on PEEK: In Vitro Study. J. Funct. Biomater. 2022, 13, 99. [Google Scholar] [CrossRef]
- Cheng, B.C.; Koduri, S.; A Wing, C.; Woolery, N.; Cook, D.J.; Spiro, R.C. Porous titanium-coated polyetheretherketone implants exhibit an improved bone–implant interface: An in vitro and in vivo biochemical, biomechanical, and histological study. Med. Devices EÉvid. Res. 2018, 11, 391–402. [Google Scholar] [CrossRef]
- Liu, C.; Zhang, Y.; Xiao, L.; Ge, X.; Öner, F.C.; Xu, H. Vacuum plasma sprayed porous titanium coating on polyetheretherketone for ACDF improves the osteogenic ability: An in vitro and in vivo study. Biomed. Microdevices 2021, 23, 21. [Google Scholar] [CrossRef]
- Kashii, M.; Kitaguchi, K.; Makino, T.; Kaito, T. Comparison in the same intervertebral space between titanium-coated and uncoated PEEK cages in lumbar interbody fusion surgery. J. Orthop. Sci. 2020, 25, 565–570. [Google Scholar] [CrossRef] [PubMed]
- Han, C.-M.; Lee, E.-J.; Kim, H.-E.; Koh, Y.-H.; Kim, K.N.; Ha, Y.; Kuh, S.-U. The electron beam deposition of titanium on polyetheretherketone (PEEK) and the resulting enhanced biological properties. Biomaterials 2010, 31, 3465–3470. [Google Scholar] [CrossRef] [PubMed]
- Walsh, W.R.; Pelletier, M.H.; Christou, C.; He, J.; Vizesi, F.; Boden, S.D. The in vivo response to a novel Ti coating compared with polyether ether ketone: Evaluation of the periphery and inner surfaces of an implant. Spine J. 2018, 18, 1231–1240. [Google Scholar] [CrossRef]
- Wu, C.-Y.; Tu, K.-J.; Deng, J.-P.; Lo, Y.-S.; Wu, C.-H. Markedly Enhanced Surface Hydroxyl Groups of TiO2 Nanoparticles with Superior Water-Dispersibility for Photocatalysis. Materials 2017, 10, 566. [Google Scholar] [CrossRef]
- Zheng, T.; Wu, C.; Zhang, Y.; Chen, M.; Cummings, P.T. Molecular Investigation of the Initial Nucleation of Calcium Phosphate on TiO2 Substrate: The Effects of Surface Nanotopographies. Cryst. Growth Des. 2018, 18, 3283–3290. [Google Scholar] [CrossRef]
- Yang, Y.-J.; Tsou, H.-K.; Chen, Y.-H.; Chung, C.-J.; He, J.-L. Enhancement of bioactivity on medical polymer surface using high power impulse magnetron sputtered titanium dioxide film. Mater. Sci. Eng. C 2015, 57, 58–66. [Google Scholar] [CrossRef]
- Tsou, H.-K.; Chi, M.-H.; Hung, Y.-W.; Chung, C.-J.; He, J.-L. In Vivo Osseointegration Performance of Titanium Dioxide Coating Modified Polyetheretherketone Using Arc Ion Plating for Spinal Implant Application. BioMed Res. Int. 2015, 2015, 328943. [Google Scholar] [CrossRef]
- Shimizu, T.; Fujibayashi, S.; Yamaguchi, S.; Otsuki, B.; Okuzu, Y.; Matsushita, T.; Kokubo, T.; Matsuda, S. In vivo experimental study of anterior cervical fusion using bioactive polyetheretherketone in a canine model. PLoS ONE 2017, 12, e0184495. [Google Scholar] [CrossRef] [PubMed]
- Lu, T.; Wen, J.; Qian, S.; Cao, H.; Ning, C.; Pan, X.; Jiang, X.; Liu, X.; Chu, P.K. Enhanced osteointegration on tantalum-implanted polyetheretherketone surface with bone-like elastic modulus. Biomaterials 2015, 51, 173–183. [Google Scholar] [CrossRef] [PubMed]
- Liu, X.; Gan, K.; Liu, H.; Song, X.; Chen, T.; Liu, C. Antibacterial properties of nano-silver coated PEEK prepared through magnetron sputtering. Dent. Mater. 2017, 33, e348–e360. [Google Scholar] [CrossRef] [PubMed]
- Liu, W.; Li, J.; Cheng, M.; Wang, Q.; Qian, Y.; Yeung, K.W.; Chu, P.K.; Zhang, X. A surface-engineered polyetheretherketone biomaterial implant with direct and immunoregulatory antibacterial activity against methicillin-resistant Staphylococcus aureus. Biomaterials 2019, 208, 8–20. [Google Scholar] [CrossRef] [PubMed]
- Ajami, E.; Fu, C.; Wen, H.B.; Bassett, J.; Park, S.J.; Pollard, M. Early Bone Healing on Hydroxyapatite-Coated and Chemically-Modified Hydrophilic Implant Surfaces in an Ovine Model. Int. J. Mol. Sci. 2021, 22, 9361. [Google Scholar] [CrossRef]
- George, S.M.; Nayak, C.; Singh, I.; Balani, K. Multifunctional Hydroxyapatite Composites for Orthopedic Applications: A Review. ACS Biomater. Sci. Eng. 2022, 8, 3162–3186. [Google Scholar] [CrossRef]
- Hu, F.; Fan, X.; Peng, F.; Yan, X.; Song, J.; Deng, C.; Liu, M.; Zeng, D.; Ning, C. Characterization of Porous Titanium-Hydroxyapatite Composite Biological Coating on Polyetheretherketone (PEEK) by Vacuum Plasma Spraying. Coatings 2022, 12, 433. [Google Scholar] [CrossRef]
- Kang, J.; Zheng, J.; Hui, Y.; Li, D. Mechanical Properties of 3D-Printed PEEK/HA Composite Filaments. Polymers 2022, 14, 4293. [Google Scholar] [CrossRef] [PubMed]
- Zhu, C.; He, M.; Mao, L.; Li, T.; Zhang, L.; Liu, L.; Feng, G.; Song, Y. Titanium-interlayer mediated hydroxyapatite coating on polyetheretherketone: A prospective study in patients with single-level cervical degenerative disc disease. J. Transl. Med. 2021, 19, 14. [Google Scholar] [CrossRef] [PubMed]
- Zhu, C.; He, M.; Mao, L.; Yang, H.; Hu, B.; Zhang, L.; Feng, G.; Liu, L.; Song, Y. Titanium interlayer-mediated hydroxyapatite-coated polyetheretherketone cage in transforaminal lumbar interbody fusion surgery. BMC Musculoskelet. Disord. 2021, 22, 918. [Google Scholar] [CrossRef] [PubMed]
- Lee, J.H.; Jang, H.L.; Lee, K.M.; Baek, H.-R.; Jin, K.; Noh, J.H. Cold-spray coating of hydroxyapatite on a three-dimensional polyetheretherketone implant and its biocompatibility evaluated by in vitro and in vivo minipig model. J. Biomed. Mater. Res. Part B Appl. Biomater. 2017, 105, 647–657. [Google Scholar] [CrossRef] [PubMed]
- Dong, T.; Duan, C.; Wang, S.; Gao, X.; Yang, Q.; Yang, W.; Deng, Y. Multifunctional Surface with Enhanced Angiogenesis for Improving Long-Term Osteogenic Fixation of Poly(ether ether ketone) Implants. ACS Appl. Mater. Interfaces 2020, 12, 14971–14982. [Google Scholar] [CrossRef]
- Lyu, Z.; Zhao, Y.; Huo, S.; Wang, F.; Meng, X.; Yuan, Z.; Long, T.; Wang, Y. Mussel-inspired dopamine-CuII coated polyetheretherketone surface with direct and immunomodulatory effect to facilitate osteogenesis, angiogenesis, and antibacterial ability. Mater. Des. 2022, 222, 111069. [Google Scholar] [CrossRef]
- Wang, X.; Ma, N.; Feng, L.; Shen, M.; Zhou, Y.; Zhang, X.; Huang, R.; Zhou, L.; Ji, S.; Lou, Y.; et al. Fabrication of bFGF/polydopamine-loaded PEEK implants for improving soft tissue integration by upregulating Wnt/β-catenin signaling. Heliyon 2023, 9, e14800. [Google Scholar] [CrossRef]
- Xiao, T.; Fan, L.; Liu, R.; Huang, X.; Wang, S.; Xiao, L.; Pang, Y.; Li, D.; Liu, J.; Min, Y. Fabrication of Dexamethasone-Loaded Dual-Metal–Organic Frameworks on Polyetheretherketone Implants with Bacteriostasis and Angiogenesis Properties for Promoting Bone Regeneration. ACS Appl. Mater. Interfaces 2021, 13, 50836–50850. [Google Scholar] [CrossRef]
- Qiu, J.; Geng, H.; Wang, D.; Qian, S.; Zhu, H.; Qiao, Y.; Qian, W.; Liu, X. Layer-Number Dependent Antibacterial and Osteogenic Behaviors of Graphene Oxide Electrophoretic Deposited on Titanium. ACS Appl. Mater. Interfaces 2017, 9, 12253–12263. [Google Scholar] [CrossRef]
- Yan, J.-H.; Wang, C.-H.; Li, K.-W.; Zhang, Q.; Yang, M.; Di-Wu, W.-L.; Yan, M.; Song, Y.; Ba, J.-J.; Bi, L.; et al. Enhancement of surface bioactivity on carbon fiber-reinforced polyether ether ketone via graphene modification. Int. J. Nanomed. 2018, 13, 3425–3440. [Google Scholar] [CrossRef]
- Ouyang, L.; Deng, Y.; Yang, L.; Shi, X.; Dong, T.; Tai, Y.; Yang, W.; Chen, Z.-G. Graphene-Oxide-Decorated Microporous Polyetheretherketone with Superior Antibacterial Capability and In Vitro Osteogenesis for Orthopedic Implant. Macromol. Biosci. 2018, 18, e1800036. [Google Scholar] [CrossRef] [PubMed]
- Oladapo, B.I.; Ismail, S.O.; Ikumapayi, O.M.; Karagiannidis, P.G. Impact of rGO-coated PEEK and lattice on bone implant. Colloids Surf. B Biointerfaces 2022, 216, 112583. [Google Scholar] [CrossRef] [PubMed]
- Ren, Y.; Sikder, P.; Lin, B.; Bhaduri, S.B. Microwave assisted coating of bioactive amorphous magnesium phosphate (AMP) on polyetheretherketone (PEEK). Mater. Sci. Eng. C 2018, 85, 107–113. [Google Scholar] [CrossRef]
- Takaoka, Y.; Fujibayashi, S.; Yabutsuka, T.; Yamane, Y.; Ishizaki, C.; Goto, K.; Otsuki, B.; Kawai, T.; Shimizu, T.; Okuzu, Y.; et al. Synergistic effect of sulfonation followed by precipitation of amorphous calcium phosphate on the bone-bonding strength of carbon fiber reinforced polyetheretherketone. Sci. Rep. 2023, 13, 1443. [Google Scholar] [CrossRef] [PubMed]
- Gao, A.; Liao, Q.; Xie, L.; Wang, G.; Zhang, W.; Wu, Y.; Li, P.; Guan, M.; Pan, H.; Tong, L.; et al. Tuning the surface immunomodulatory functions of polyetheretherketone for enhanced osseointegration. Biomaterials 2020, 230, 119642. [Google Scholar] [CrossRef]
- Dai, Y.; Guo, H.; Chu, L.; He, Z.; Wang, M.; Zhang, S.; Shang, X. Promoting osteoblasts responses in vitro and improving osteointegration in vivo through bioactive coating of nanosilicon nitride on polyetheretherketone. J. Orthop. Transl. 2019, 24, 198–208. [Google Scholar] [CrossRef]

| Materials | Elastic Modulus (GPa) | Yield Strength (MPa) |
|---|---|---|
| Human Cortical bone | 11.5–18 | 51–33 |
| Human Trabecular Bone | 0.3–3.2 | 2–17 |
| Titanium (Ti) | 100–110 | 250–320 |
| PEEK | 3–4 | 90–100 |
Disclaimer/Publisher’s Note: The statements, opinions and data contained in all publications are solely those of the individual author(s) and contributor(s) and not of MDPI and/or the editor(s). MDPI and/or the editor(s) disclaim responsibility for any injury to people or property resulting from any ideas, methods, instructions or products referred to in the content. |
© 2023 by the authors. Licensee MDPI, Basel, Switzerland. This article is an open access article distributed under the terms and conditions of the Creative Commons Attribution (CC BY) license (https://creativecommons.org/licenses/by/4.0/).
Share and Cite
Liu, S.; Sui, J.; Chen, K.; Ding, Y.; Chang, X.; Hou, Y.; Zhang, L.; Meng, X.; Xu, Z.; Miao, L.; et al. Surface Modification Techniques for Polyetheretherketone as Spinal Interbody Fusion Cage Material to Stimulate Biological Response: A Review. Coatings 2023, 13, 977. https://doi.org/10.3390/coatings13060977
Liu S, Sui J, Chen K, Ding Y, Chang X, Hou Y, Zhang L, Meng X, Xu Z, Miao L, et al. Surface Modification Techniques for Polyetheretherketone as Spinal Interbody Fusion Cage Material to Stimulate Biological Response: A Review. Coatings. 2023; 13(6):977. https://doi.org/10.3390/coatings13060977
Chicago/Turabian StyleLiu, Shu, Junhao Sui, Kai Chen, Yun Ding, Xinyu Chang, Yijin Hou, Lin Zhang, Xiangyu Meng, Zihao Xu, Licai Miao, and et al. 2023. "Surface Modification Techniques for Polyetheretherketone as Spinal Interbody Fusion Cage Material to Stimulate Biological Response: A Review" Coatings 13, no. 6: 977. https://doi.org/10.3390/coatings13060977
APA StyleLiu, S., Sui, J., Chen, K., Ding, Y., Chang, X., Hou, Y., Zhang, L., Meng, X., Xu, Z., Miao, L., Huo, S., Wang, G., & Shi, Z. (2023). Surface Modification Techniques for Polyetheretherketone as Spinal Interbody Fusion Cage Material to Stimulate Biological Response: A Review. Coatings, 13(6), 977. https://doi.org/10.3390/coatings13060977






